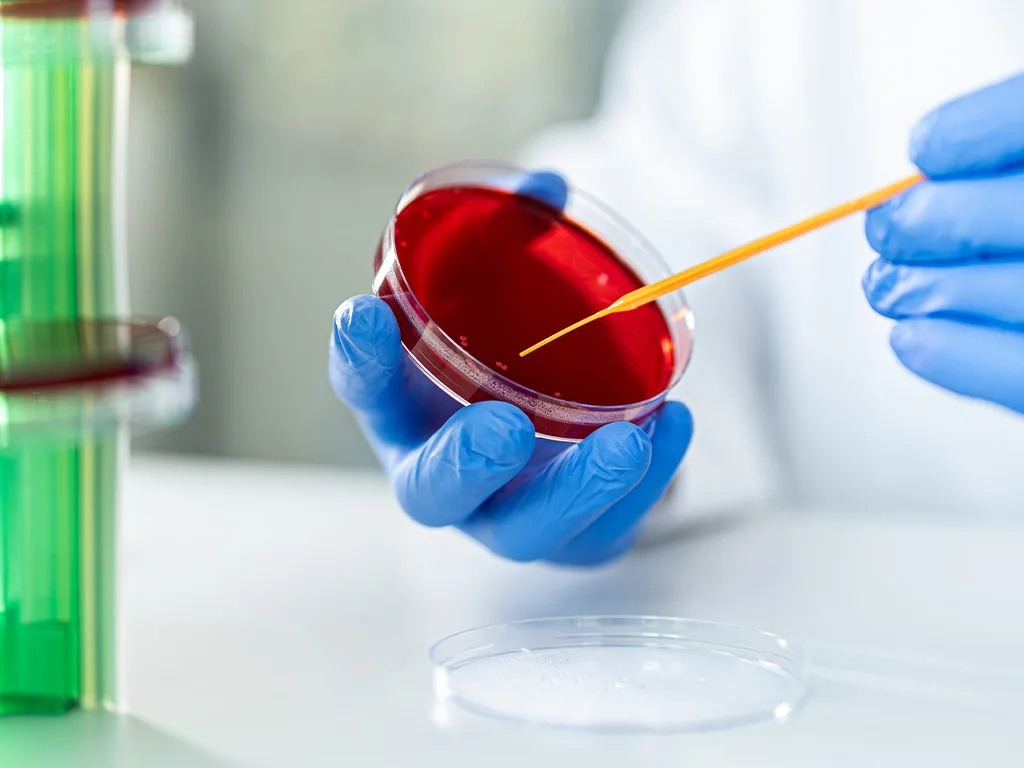
PRO-LA-Microbiology-Petrischale

Microbiology
In particular, the working steps required to prepare the culture medium dishes before applying the samples can be made more transparent, safer and more efficient with a Petri Dish Organisation System. Mix-ups are avoided with a constantly high throughput. Our Petri Dish Transfer System enables laboratory processes to be shortened considerably by automatically transporting sets of dishes to the workstation.
Petri Dish Orga System
With POS 720/2, up to 700 Petri dishes per hour are labelled and stacked in sets in a fully automatic process.
Designed to accommodate 600 dishes (15 magazines of 40 dishes each), the system stands out for its high capacity and flexibility.
Labelling errors in microbiology laboratories are reduced and processing procedures are made simple and consistent, improving quality and competitiveness.
Labour-saving and easy to operate
Reliable provision of all required Petri dishes
Consistent barcode labelling and clear alphanumeric printing
Reliable identification of dishes throughout the process
Additional labels for special media and bouillons available at the workstation

Petri Dish Transfer System PTS
The Petri Dish Transfer System PTS transports the dish stacks pre-sorted by the POS 720/2 to the individual workstations. The free-standing system provides customised solutions and is adjustable in height within a defined range. Laboratory tables and benches can be conveniently positioned close to the PTS. Exit points on the track ensure that stacks are correctly assigned to the relevant workstations.
Customised configuration of the track length and concept
Labour-saving and easy to operate
Reliable provision of all required Petri dishes
Reliable identification of dishes throughout the process
Additional labels for special media and bouillons available at the workstations

Consumables for Microbiology
Made from crystal-clear polystyrene, our Petri dishes for use with hot agar are heat-resistant to 80 °C. Thanks to their enhanced dimensional stability, they are particularly suited for all automated processing steps from labelling, stacking, streaking, and incubation, to automated analysis.
Downloads
Your partner for laboratory automation
For over 25 years, we have been developing, manufacturing and distributing intelligent automation solutions for diagnostic laboratories. Our modular and flexibly adaptable systems can be seamlessly integrated into existing laboratory structures – tailored precisely to your processes and with the aim of noticeably reducing your team's workload.
